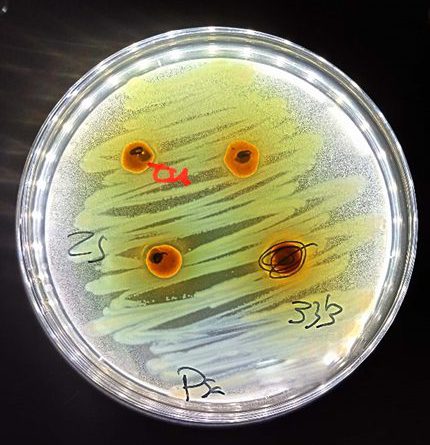

InnDIH atrae a 200 empresas y agentes de innovación para hablar de transformación digital en la jornada final de resultados del proyecto
· El evento final de InnDIH reunió el 18 de noviembre en CaixaForum Valencia a las cerca de 50 entidades
+ Leer más